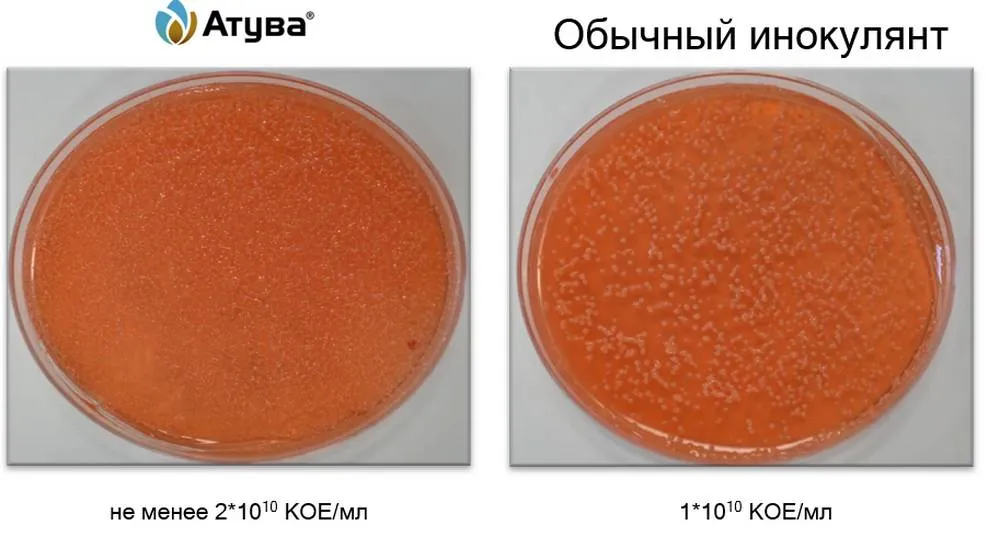

7 февраля 2023, Вторник, 10:10
Инокулянт последнего поколения АТУВА®
В современном аграрном сообществе ведется ожесточенная дискуссия о применении инокулянтов в технологии товарного производства сои и об эффективности биологической фиксации азота как таковой. Предлагаем основательно разобраться в теме, чтобы осталось как можно меньше вопросов.
Для чего нужна инокуляция
Соя — чуть ли не самая важная бобовая культура. Но она очень требовательна к элементам питания. Кроме того, их усвоение растениями в разные фазы развития происходит неравномерно.

По данным многолетних испытаний, проведенных в 1980–2010 годах, соя тем продуктивнее, чем больше азота поступает в растение.

Сое для формирования урожайности, например, 3 т/га необходимо около 240 кг азота. Приблизительно 80 кг культура способна усвоить за счет естественного плодородия почвы, остальные 160 кг необходимо будет компенсировать внесением минеральных элементов. В зависимости от выбранного удобрения это будет приблизительно 400–500 кг в физическом весе, что составляет 8,5–10 тыс. руб/га. Такие вложения в условиях современного рынка цен на «минералку» неоправданно высокие и обязательно скажутся на маржинальности культуры в хозяйстве.
Согласно исследованию Международного института питания растений (IPNI), проведенному с 1955 по 2017 год, инокулянты способны обеспечить растениям за счет биологической фиксации азота до 80 % их потребности в нем и без применения минеральных удобрений. Соя в условиях исследования сформировала урожайность на уровне 4,5 т/га, и для России это очень высокий показатель.
Сразу остановимся на еще одном моменте. В почве находится довольно большое количество клубеньковых бактерий, которые способны заселить корневую систему. Но экономического эффекта они не дадут, так как активность нитрогеназы у них крайне мала — 2.86 µM.g-1 h-1. Бактерии в основном заселяют вторичные корни, следовательно, работают неэффективно и не способны обеспечить растение необходимым количеством азота.

При инокуляции образование клубеньков происходит на главном корне, где они работают в 12 раз продуктивнее по сравнению с клубеньками на вторичных корнях, поскольку концентрация нитрогеназы у них составляет 36 µM.g-1.h-1.
Таким образом, единственно верным решением хозяйственника, желающего повысить урожайность сои, будет производить инокуляцию семян.
На первый взгляд кажется, что все инокулянты одинаковы, ведь на протяжении многих лет в них использовался один или два вида бактерий рода Bradyrhizobium. Практически все инокулянты представляли собой сухой порошокс низким титром — 1–105–7 КОЕ/мл. Перед применением нужно было еще постараться растворить его в воде и каким-то образом нанести на семена. Они имели высокие нормы расхода (около 4–5 кг/л на тонну семян), боялись даже малейшего попадания прямых солнечных лучей, а посев необходимо было проводить сразу после обработки, так как бактерии не могли долго сохраняться на поверхности семян. О совместимости инокулянтов с химическими препаратами нельзя было и мечтать.
Но технологии не стоят на месте, и на рынке появился высококонцентрированный инокулянт последнего поколения АТУВА®, который способен обеспечить до 80 % потребности сои в азоте при уровне урожайности 3 т/га.
АТУВА® содержит два высокоэффективных штамма Bradyrhizobium japonicum, 5079 и 5080, адаптированных к российским почвам, которые обеспечивают сою необходимым азотом в критические фазы развития, что способствует увеличению урожая и снижению себестоимости продукции. Инокулянт имеет высокую концентрацию бактерий (титр 2 × 1010 КОЕ/мл), что позволяет обеспечить длительный (до 30 дней) процесс заселения корневой системы даже в засушливых условиях и при низком рН почвы (до 4,7).
В комплекте с инокулянтом АТУВА® идет экстендер ПРЕМАКС, специальная формуляция которого предотвращает слипание семян после обработки.
Низкая норма расхода инокулянта позволяет уменьшить общий объем рабочей жидкости, что ускоряет время высыхания семян и улучшает их сыпучесть, а также при приготовлении баковой смеси рабочий раствор АТУВА® можно использовать вместо воды.
И самое главное: инокулянт АТУВА® разрешен для совместного применения в баковых смесях с препаратами компании «Сингента».
Подробнее остановимся на достижениях ученых «Сингенты», которые теперь доступны всем без исключения сельхозпроизводителям России.
Ученые компании «Сингента» пять лет назад выделили из почв всех основных сельскохозяйственных регионов России дикие формы штаммов бактерий Bradyrhizobium japonicum. После длительной селекции при помощи генной инженерии были созданы два культурных штамма, 5079 и 5080, которые переняли от своих диких форм высокую выживаемость и адаптивность к неблагоприятным факторам, приобрели способность к созданию интенсивного симбиоза с растениями сои и могут обеспечивать их азотным питанием до 80 % от потребности. По международной классификации бактерий цифра 5, стоящая в начале номера штамма, показывает, что он относится к новейшему поколению селекции данного рода. Она присваивается только тем штаммам, которые несут максимальное количество полезных сельскохозяйственных признаков. Данный род бактерий фиксирует на 25 % больше азота из воздуха по сравнению с другими.
Ученые разработали специальную технологию производства инокулянта АТУВА®. Она включает в себя «закалку» бактерий на этапе их роста в биологическом реакторе, в котором искусственно повышают температуру, изменяют рH среды, давление, добавляют химические препараты. В результате:
- увеличивается толщина клеточных стенок бактерий;

- в два раза повышается концентрация бактерий в миллилитре;
Посев бактерий, отобранных из заводской упаковки, после ряда разведений в лабораторный условиях. На фото видно более высокую концентрацию колоний культурных штаммов Bradyrhizobium japonicum по сравнению с конкурентом
- до двух лет увеличивается срок хранения препарата в оригинальной закрытой упаковке.
Формирование плотной клеточной стенки и повышенный титр усиливают устойчивость бактерий к неблагоприятным факторам внешней среды и химическим препаратам для защиты семян даже при совместной обработке в одной баковой смеси.
Экстендер ПРЕМАКС, применяемый совместно с инокулянтом АТУВА®, выполняет ряд функций:
- обеспечивает бактерии на семенах питанием для поддержания их в активном состоянии после обработки и до момента заселения корневой системы сои;
- устойчиво закрепляет бактерии на семенах за счет вспененной структуры;

Под микроскопом видно вспененную структуру экстендера ПРЕМАКС, которая позволяет бактериям лучше закрепляться на гладкой поверхности семян
- предотвращает высыхание бактерий на семенах, тем самым продлевает срок между обработкой и посевом.
Все вышеперечисленные аспекты приводят к тому, что бактерии, входящие в состав инокулянта АТУВА®, способны жить на поверхности семени после обработки 21 день без количественных изменений (6 000 000 шт/семя).

Высокая концентрация бактерий обеспечивает полное заселение ими корневой системы и образование количества клубеньков, достаточного для бездефицитного азотного питания сои в критические фазы роста.

Специальная селекция бактерий и их высокая концентрация на семенах способствуют увеличению количества клубеньков на одном растении и их веса.

Исследования подтвердили, что инокулянт АТУВА® многократно увеличивает урожайность сои и, соответственно, прибыль по сравнению с внесением предпосевных доз минеральных азотных удобрений и использованием инокулянтов с низким титром бактерий. Ниже произведен расчет экономической эффективности, который показывает прибавку 9 450 руб/га по сравнению с контролем и практически двойную прибавку по сравнению с применением обычных инокулянтов.

Исследованиями доказано, что АТУВА® остается более экономически выгодным продуктом по сравнению с другими инокулянтами, что обуславливается большей азотфиксирующей способностью бактерий Bradyrhizobium japonicum штаммов 5079 и 5080 и их высоким титром 2 × 1010 КОЕ/мл.

Прибавка в урожайности — 2,3–6,3 ц/га по сравнению с другими инокулянтами. Много это или мало? Посчитайте, умножив прибавку на стоимость, и вывод можете сделать сами.








